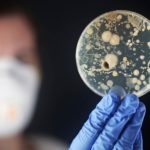
Des bactéries ultra-résistantes tuent 8 000 Japonais par an

C’est une première au Japon, le 1er juillet la préfecture d’Ibaraki est devenu le premier département japonais à reconnaître légalement l’union entre deux personnes du même sexe avec le bénéfice des mêmes droits que les couples mariés. La brèche d’une nouvelle ère pour l’archipel ?
La délivrance de « partenariat enregistré » pour valider l’union de personnes du même sexe existait déjà à l’échelle locale dans six villes japonaises : Osaka, Fukuoka, Sapporo, Naha, Iga, Takarazuka ainsi que trois arrondissements tokyoïtes : Shibuya, Setagaya, Nakano. Jusqu’à aujourd’hui, aucun département ne reconnaissait le mariage des couples homosexuels dans tout l’archipel.
Depuis cette semaine, tous les couples LGBT+ qui le signeront ce partenariat à Ibaraki pourront bénéficier de droits qui leur étaient jusque là refusés. Ainsi, lors d’une demande de logement auprès de la préfecture, ils seront traités et reconnus de la même manière qu’un couple marié (droits égaux). La mairie de Tokyo avait adopté en octobre dernier une loi contre la discrimination des personnes LGBT+ prônant notamment une égalité élémentaire de traitement, mais sa portée demeure locale sans effet vraiment concret. Par cette décision, la préfecture d’Ibaraki passe de la parole politique aux actes dans une concrétisation d’une égalité institutionnelle.
https://www.instagram.com/p/BeS3znOn5Kl/
Cette décision intervient alors que l’opinion publique japonaise se positionne désormais majoritairement pour l’union entre personnes du même sexe. Lors d’un sondage effectué par le cabinet Dentsu en octobre dernier 78% des Japonais interrogés s’y déclaraient favorables. Le décalage entre la mentalité japonaise moderne et le poids des institutions anciennes est manifeste. Pour autant, nombreux sont les Japonais – particulièrement âgés – à mal percevoir l’homosexualité chez un voisin, un collègue ou son propre enfant, générant des discriminations sociales.
Les personnes homosexuelles demeurent ainsi victimes de discriminations les incitant à cacher leur orientation sexuelle de peur d’être rejeté. Être différent dans une société japonaise très uniformisée relève d’un défi au quotidien. Pour donner son sang, une personne homosexuelle doit attendre un délais de 6 mois contrairement aux personnes hétérosexuelles (surfant sur cette vieille idée qu’une personne homosexuelle est potentiellement porteuse de MST). Plus grave, les couples LGBT+ ne peuvent hériter de leur conjoint ou bénéficier des mêmes avantages fiscaux que les couples mariés. En cas d’hospitalisation, le conjoint n’a légalement même pas de droit de visite ! Il n’existe pas aux yeux de nombreuses institutions japonaises…
Mais l’exemple de courage donné par la préfecture d’Ibaraki – située à environ 1 heure de train de Tokyo – montre que les mentalités évoluent lentement mais sûrement vers la voie de la tolérance et de l’acceptation. Ce qui laisse augurer qu’à moyen terme, il n’y aura plus de différence de traitement entre les couples, qu’ils soient ou non du même sexe. Une idée qui semble toujours pétrifier tous les réactionnaires de ce monde.
https://www.instagram.com/p/Bqecy5yHhPI/
S. Barret
Pour un média libre et indépendant sur le Japon, soutenez Poulpy sur Tipeee !